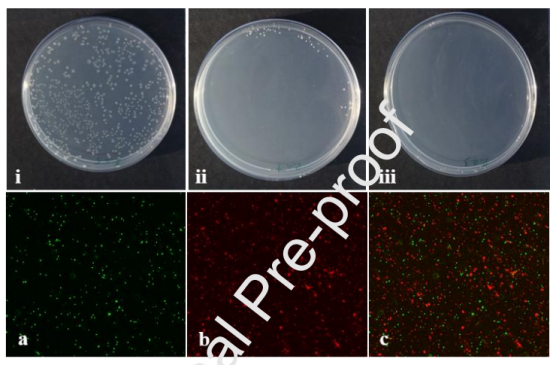

DOI:10.1016/j.ijbiomac.2020.12.025
皮肤是人体的保护层,由于创伤、事故、压力和危险暴露等多种因素,皮肤往往容易受到损伤。这就需要皮肤的自我再生和修复能力,该修复期是一个非常精细的调节过程。为了加速这一过程并防止进一步损伤,敷料是至关重要的。在此,研究者制备了聚-3-羟基丁酸(P)-海藻酸钠(S)(核-壳)纳米纤维基质,作为切除伤口模型中皮肤组织再生的保护性支架。使用同轴静电纺丝将精氨酸(A)和层状双氢氧化物-杆菌肽(LB)掺入纳米纤维基质的核和壳中。核壳纳米纤维有助于L-精氨酸和杆菌肽的协同受控递送,分别在伤口部位的蛋白质合成、细胞信号传导和感染控制中发挥着主要作用。通过对真皮成纤维细胞的测试证实了其体外生物相容性。此外,体内研究表明这两种成分在伤口的积极愈合中具有协同作用。生化、组织学和免疫组化研究表明,精氨酸负载支架有助于细胞迁移和增殖。上述结果表明,壳、核中杆菌肽-纳米粘土复合物和L-精氨酸的同时存在为支架提供了可促进伤口愈合的动态特性。

图1.具有不同S:PVA比例的PS纳米纤维支架的SEM:(a)3:7,(b)6:4,(c)7:3,(d)PA-SLB纳米纤维支架的横截面SEM图。

图2.支架的傅立叶变换红外光谱:精氨酸负载聚(3-羟基丁酸)(核)(PA);海藻酸钠与LDH-bac(壳)(SLB);PA-SLB:核壳。

图3.支架的孔隙率。***表示经单向ANOVA分析,当P<0.001时差异具有统计学意义。

图4.支架在60小时内的溶胀率。结果表示为平均值±SE。

图5.在30s时电纺支架的水接触角,显示了不同支架的水滴变化。

图6.从PA-SLB支架的核-壳组分释放出精氨酸和杆菌肽的模式。插图显示了杆菌肽单独释放和LDH-杆菌肽释放的差异。
图7.所制备的支架对金黄色葡萄球菌的抗菌作用。i-iii显示培养板照片,以评估微生物培养物与支架相互作用后菌落形成单位的数量。经金黄色葡萄球菌处理支架(PA-SLB)的荧光显微镜图像(放大倍数=10X),显示活细胞(a,绿色),死细胞(b,红色)和合并(vi)。

图8.[a]支架对NIH3T3成纤维细胞系活性的影响。所有实验均一式三份进行,并使用t检验分析均值±SE;**P<0.05表示统计学显著差异,[b]体外荧光显微镜图像显示培养24小时后的细胞活性,放大倍数为40倍。

图9.显示了从第0天到第20天以相同距离拍摄的切除伤口愈合模式的照片。

图10.(a)20天的伤口闭合率。(b)在康复期间动物体重的变化。***P<0.001表示显著性差异。

图11.对照(a,c)和PA-SLB(b,d)处理动物的组织学图像。对照(e,g)和PA-SLB(f,h)处理动物的Masson三色染色。

图12.用支架PA-S和PA-SLB处理的伤口组织切片的免疫组织化学染色,显示了VEGF的表达,VEGF是愈合过程中的重要生长因子。

图13.伤口愈合的指标:(a)治疗动物组织中羟脯氨酸的水平。(b)治疗动物组织中的尿酸水平。(c)治疗动物组织中己糖胺的水平。***P<0.001表示显著性水平。

图14.对照组和治疗组离体愈合伤口组织的抗张强度值。与对照组相比,数值表示为平均值±SD,显著性水平表示为***P<0.001。
